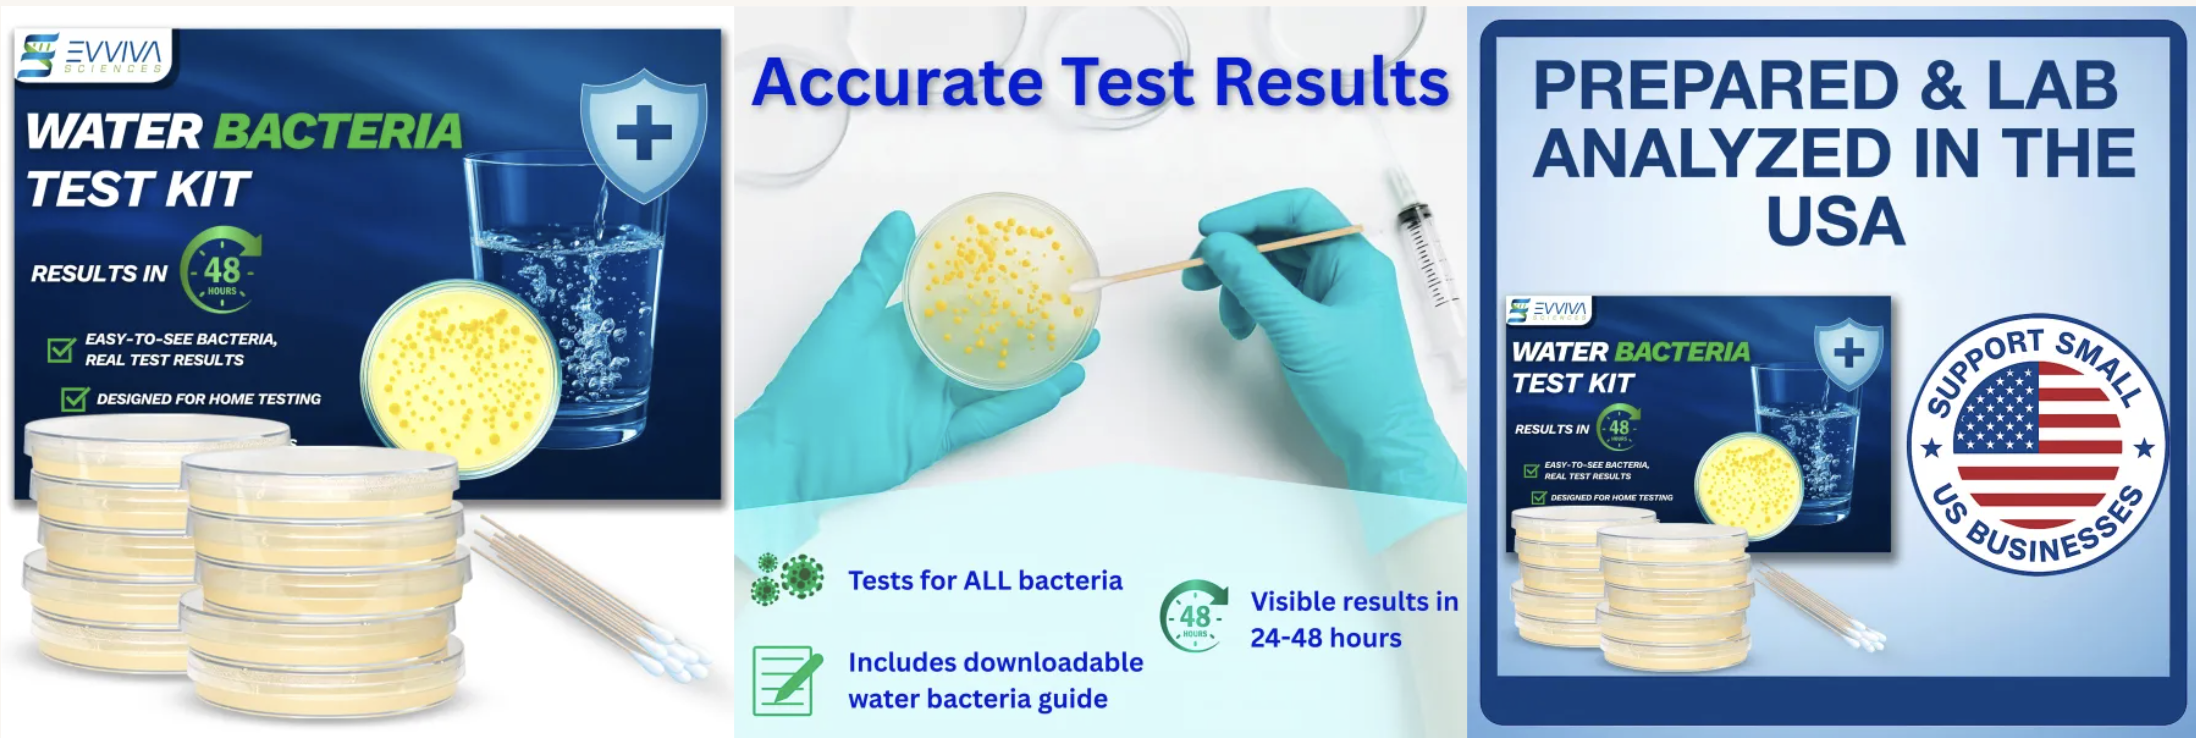

Alex Giacomini
Content Writer / Copywriter / Campaign Manager
Editorial and Journalism
Making Complex Ideas Human
From consumer psychology on Medium to peer-reviewed neuroscience at Stanford Medicine, Alex brings the same discipline to every format: make it clear, make it matter, make it land.
Medium
3 Reasons Why You're Addicted to Heartbreak (And Why Sad Movies Feel So Good)
A psychology-meets-pop-culture piece exploring why audiences seek out emotional pain through fiction. Draws on Aristotle's catharsis, the neuroscience of dopamine and oxytocin reward cycles, and the psychology of voluntary choice. Science-backed, widely shared, and written for a general audience.
Stanford University School of Medicine
The Power of Music: How Music Training in High School Helps Brain Development
Reporting on a Northwestern University study published in PNAS, this article made the case for music education in public schools by synthesizing peer-reviewed neuroscience for a non-specialist readership, balancing scientific accuracy with an accessible, urgent narrative.



Stanford University School of Medicine
The Power of Music: How Music Training in High School Helps Brain Development
Article translating a University of Florida study on Type 1 diabetes into an accessible, human-centered narrative. The piece highlights how children used photography to document the daily realities of managing their condition, revealing both the physical toll and emotional weight of chronic illness.
Results That Speak For Themselves
Across science education, interactive entertainment, and mobile content, every campaign is anchored to outcomes: retention, revenue, and reach.

Evviva Sciences
Product Marketing: Science Made Sellable
As the sole marketing coordinator at Evviva Sciences, a 15-person science education company with $2M ARR, Alex owns the full campaign lifecycle, from go-to-market planning through asset delivery, translating laboratory science into copy that converts.
E-COMMERCE COPY
Water Bacteria Test Kit
Customer-facing copy and go-to-market strategy making water safety science feel urgent, simple, and trustworthy to a general consumer who has never used a lab-grade test before.
Translated agar plate, coliform, and E. coli detection into accessible consumer language
Wrote urgency-driven copy anchored in health and safety messaging
Coordinated with lab and fulfilment teams to ensure accurate, on-brand claims
Supported competitive pricing research and audience positioning

E-COMMERCE COPY
Mold Test Kit with US-Based Lab Analysis
Go-to-market copy strategy for a premium mold detection kit with professional lab analysis and return shipping. Positioned lab-backed results as the key differentiator over DIY alternatives.
Differentiated professional lab analysis from basic DIY mold tests in messaging
Made HVAC and surface detection science clear to a non-technical buyer
Created consistent content across web, email, and e-commerce
Managed deliverables across product, lab, packaging, and fulfillment teams.
Over 7 Years of Content at Scale
As Senior Writer, Team Lead, and Editor at Crazy Maple Studio, Alex directed 20+ large-scale digital projects for a platform with 1 million daily active users. She built and mentored a team of 12+ writers, established brand voice standards, increased user retention by 14%, and scaled production output by 50%.

Chapters: Interactive Stories
Social Copywriting That Builds Fandoms
As Senior Writer, Team Lead, and Editor at Crazy Maple Studio, Alex directed 20+ large-scale projects for a platform with 1M daily active users, built and mentored a team of 12+ writers, increased user retention by 14%, and scaled production output by 50%. Below: title performance, then direct Instagram examples sorted by engagement.
Coming Soon Teaser 16,044 views

A Crane Family Christmas 6K likes

Halo 2.5K likes

Claimed by the Alpha 1.3K likes

Snow Falling 2.6K likes

I was Kidnapped by the Pirate King 978 likes

Sold to the Alpha Kings 1,398 likes
